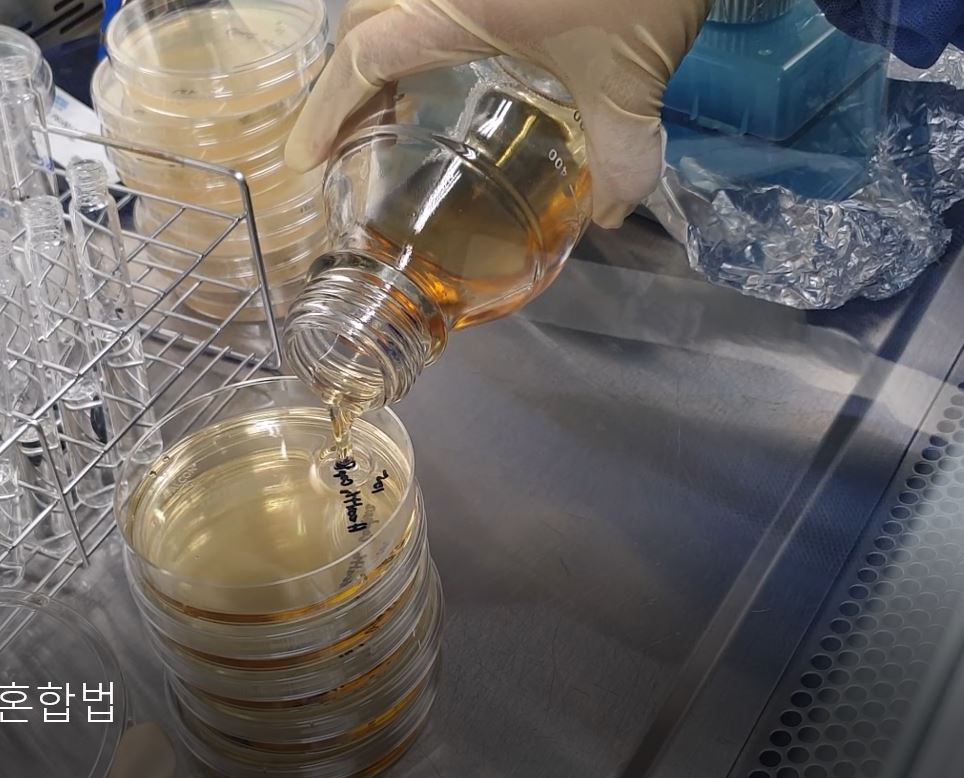

한천평판법 한천평판법은 각 배지에 대하여 적어도 2 개의 평판을 써서 시험하며 결과는 각 평판의 측정균수의 평균값을 사용한다.
가. 한천평판혼합법 지름 9 cm의 페트리접시를 쓸 때는 페트리접시에 검체 존재하의 측정법의 적합성 항목의 ① ~ ③항에 따라 조제한 검체 1 mL 및 미리 45 ℃ 이하로 보온한 15 ~ 20 mL의 대두카제인소화한천배지 또는 사브로포도당한천배지를 넣는다. 보다 큰 페트리접시를 쓸 때에는 크기에 맞게 한천배지량을 증가한다. 표 I-1에 제시한 미생물마다 적어도 2 개의 페트리접시를 쓴다. 표 I-1에 기재한 조건으로 평판배지를 배양한다. 배지마다 균주의 산술평균을 가지고 집락수를 계산한다.
검체 존재 하의 측정법의 적합성
① 검액의 조제 검액의 조제법은 검체의 물리학적 특성에 의존한다. 아래에 기재한 어느 방법도 만족할 수 없을 때에는 따로 적절한 다른 방법을 확립한다.
ⅰ) 수용성제제 검체를 pH 7.0 펩톤염화나트륨완충액, pH 7.2 인산완충액 또는 대두카제인소화액체배지로 녹이거나 희석한다 (보통 10 배 희석액을 조제한다). 필요하면 pH 6 ~ 8로 조정한다. 희석이 더 필요할 때에는 같은 희석액으로 조제한다.
ⅱ) 물에 녹지 않는 비지질제제 검체를 pH 7.0 펩톤염화나트륨완충액, pH 7.2 인산완충액 또는 대두카제인소화액체배지에 현탁한다 (보통 10 배 희석액을 조제한다). 분산하기 쉽게 하기 위해 예를 들면 폴리소르베이트 80 (농도 : 1 g/L)과 같은 계면활성제를 넣을 수 있다. 필요하면 pH 6 ~ 8로 조정한다. 희석이 더 필요할 때에는 같은 희석액으로 조제한다.
ⅲ) 지질제제 검체를 여과멸균한 미리스틴산이소프로필에 녹이거나 필요하면 40 ℃ 이하 (예외적인 경우에는 45 ℃ 이하)에서 가온한 최소필요량의 멸균된 폴리소르베이트 80 또는 다른 저해성이 없는 계면활성제를 써서 혼합한다. 필요하면 수욕에서 그 온도를 유지하면서 주의깊게 섞는다. 선정한 희석액을 미리 가온하여 넣어 검체의 10 배 희석액을 조제한다. 유화에 필요한 가장 짧은 시간 동안 온도를 유지하면서 주의하여 섞는다. 적절한 농도의 멸균한 폴리소르베이트 80 또는 다른 저해성이 없는 계면활성제를 함유하는 같은 희석액으로 10 배 단계 희석계열을 조제해도 된다.
ⅳ) 에어로솔형의 액체 또는 고체 검체를 무균적으로 멤브레인필터장치에 넣거나 검체 채취를 위해 멸균용기로 옮긴다. 각 검체용기에서 전량을 쓰거나 정량분무한 일정량을 쓴다.
ⅴ) 경피흡수패취 경피흡수패취의 보호피복 (박리라이너)을 제거하고 점착면을 위로 향하게 하여 멸균유리 또는 멸균플라스틱트레이 (tray) 위에 놓는다. 패취끼리 부착하는 것을 막기 위해 멸균한 다공성물질 (예를 들면 멸균거즈)로 점착면을 덮는다. 폴리소르베이트 80 및/또는 레시틴 등의 불활성화제를 함유하는 선정한 희석액 적당량에 패취를 넣고 적어도 30 분간 세게 흔들어 섞는다.
② 접종 및 희석 100 CFU 이하의 접종균을 얻는데 충분한 양의 시험균 현탁액을 ①항에 따라 조제한 검액 및 대조액 (검체 불포함)에 넣는다. 접종하는 시험균 현탁액의 양은 검액량의 1 %를 초과하지 않도록 한다. 제품에서 허용가능한 미생물 회수결과를 얻기 위해 가장 낮은 희석배율의 검액을 가지고 시험한다. 항균활성 또는 낮은 용해도 때문에 가장 낮은 희석배율의 검액으로 시험할 수 없는 경우에는 다시 적절한 시험방법을 확립한다. 검체로 인한 증식저지를 피할 수 없는 경우에는 중화, 희석 또는 여과한 다음에 시험균 현탁액을 넣어도 된다.
③ 항균활성의 중화·제거 ② 및 ④항에 기재한 방법에 따라 시험하여 검액에서 회수한 균수와 대조액에서 회수한 균수를 비교한다. 증식이 저해되는 경우 (검액에서 회수한 균수가 대조액에서 회수한 균수의 1/2 미만인 경우)에는 결과의 유효성을 확보하기 위해 생균수 측정법을 변경한다. 방법의 변경은 예를 들어 (1) 희석액 또는 배지의 증량, (2) 특이적 또는 일반적인 중화제를 희석액에 첨가, (3) 막여과 또는 (4) 위의 측정법의 조합 등이다.
중화제 항균제의 활성을 중화하기 위해 중화제를 쓸 수 있다 (표 I-2). 중화제는 선정한 희석액 또는 배지에 멸균 전에 미리 첨가할 수 있다. 중화제를 쓴 경우에는 그 유효성과 미생물에 대한 독성이 없음을 증명하기 위해 검체를 함유하지 않고 중화제만을 넣어 공시험하여 확인한다.
적절한 중화법을 확립할 수 없는 경우에는 그 검체가 가지는 항균활성 때문에 접종균을 분리할 수 없는 것으로 간주한다. 따라서 그 검체가 접종균과 같은 종의 균이나 근연종에 오염되었을 가능성은 낮은 것으로 생각한다. 그러나 그 검체가 이들 일부 미생물만을 저해할 뿐이고, 시험균주 이외의 균주는 저해하지 않을 가능성도 있으므로 미생물의 증식과 그 허용기준에 적합한 가장 낮은 농도로 시험한다.
| 저해물질 | 중화제/중화법 |
| 글루타르알데히드, 수은제 | 아황산수소나트륨 |
| 페놀류, 알코올류, 알데히드류, 소르빈산염 | 희석 |
| 알데히드류 | 글리신 |
| 4급 암모늄 화합물, 파라옥시벤조산류, 비스-비구아니드류 | 레시틴 |
| 4급 암모늄 화합물, 파라옥시벤조산류, 요오드 | 폴리소르베이트 |
| 수은제 | 티오글리콜산염 |
| 수은제, 할로겐류, 알데히드류 | 티오황산염 |
| 에틸렌디아민테트라아세트산염 (EDTA) | 마그네슘 또는 칼슘이온 |
④ 검체에서의 미생물 회수 표 I-1 에 기재된 미생물마다 따로 시험한다. 첨가한 미생물만을 대상으로 측정한다.
표 I-1 시험균의 조제와 사용법
| 미생물 | 시험균의 조제 |
배지성능 | 제품존재 하에서의생균수 측정법의 적합성 | ||
| 총호기성 미생물수 | 총진균수 | 총호기성 미생물수 | 총진균수 | ||
| Staphylococus aureus 예를 들면, ATCC 6538, NCIMB 9518, CIP4.83, NBRC 13276 또는 KCTC 3881 |
대두카제인소화한천배지 또는 대두카제인소화액체배지 30 ~ 35 ℃ 18 ~ 24 시간 |
대두카제인소화한천배지 그리고 대두카제인소화액체배지 ≦ 100 CFU 30 ~ 35 ℃ ≦ 3 일간 |
대두카제인소화한천배지 / MPN대두카제인소화액체배지 ≦ 100 CFU 30 ~ 35 ℃ ≦ 3 일간 |
||
| Pseudomonas aeruginosa 예를 들면, ATCC 9027, NCIMB 8626, CIP 82.118, NBRC 13275 또는 KCTC 2513 |
대두카제인소화한천배지 또는 대두카제인소화액체배지 30 ~ 35 ℃ 18 ~ 24 시간 |
대두카제인소화한천배지 그리고 대두카제인소화액체배지 ≦ 100 CFU 30 ~ 35 ℃ ≦ 3 일간 |
대두카제인소화한천배지 / MPN대두카제인소화액체배지 ≦ 100 CFU 30 ~ 35 ℃ ≦ 3 일간 |
||
| Bacillus subsilis 예를 들면, ATCC 6633, NCIMB 8054, CIP 52.62, NBRC 3134 또는 KCTC 1021 |
대두카제인소화한천배지 또는 대두카제인소화액체배지 30 ~ 35 ℃ 18 ~ 24 시간 |
대두카제인소화한천배지 또는 대두카제인소화액체배지 ≦ 100 CFU 30 ~ 35 ℃ ≦ 3 일간 |
대두카제인소화한천배지 / MPN대두카제인소화액체배지 ≦ 100 CFU 30 ~ 35 ℃ ≦ 3 일간 |
||
| Candida albicans 예를 들면, ATCC 10231, NCPF 3179, IP 48.72, NBRC 1594 또는 KCTC 7965 |
사부로포도당한천배지 또는 사부로포도당액체배지 20 ~ 25 ℃ 2 ~ 3 일간 |
대두카제인소화한천배지 ≦ 100 CFU 30 ~ 35 ℃ ≦ 5일간 |
사부로포도당한천배지 ≦ 100 CFU 20 ~ 25 ℃ ≦ 5일간 |
대두카제인소화한천배지 ≦ 100 CFU 30 ~ 35 ℃ ≦ 5일간 MPN : 적용하지 않는다. |
사부로포도당한천배지 ≦ 100 CFU 20 ~ 25 ℃ ≦ 5일간 |
| Aspergillus brasiliensis 예를 들면, ATCC 16404, IMI 149007, IP 1431.83, NBRC 9455, KCTC 6317 또는 KCTC 6196 |
사부로포도당한천배지 또는 감자덱스트로오스한천배지 20 ~ 25 ℃ 5 ~ 7 일간 또는 양호한 포자형성이 인정될 때 까지 |
대두카제인소화한천배지 ≦ 100 CFU 30 ~ 35 ℃ ≦ 5 일간 |
사부로포도당한천배지 ≦ 100 CFU 20 ~ 25 ℃ ≦ 5일간 |
대두카제인소화한천배지 ≦ 100 CFU 30 ~ 35 ℃ ≦ 5 일간 MPN : 적용하지 않는다. |
사부로포도당한천배지 ≦ 100 CFU 20 ~ 25 ℃ ≦ 5 일간 |
출저- 대한약전 일반시험법
예시 동영상
https://www.youtube.com/watch?v=43vm3qseH4E
교육문의
'제약' 카테고리의 다른 글
| PIC/S Part1-제7장 위탁제조 및 시험 (0) | 2020.09.01 |
|---|---|
| 항생물질의 미생물학적 역가시험법 (2) | 2020.08.31 |
| 제약-미생물한도시험(한천평판도말법) (0) | 2020.08.31 |
| 의약품-무균시험(직접법) (0) | 2020.08.31 |
| 무균시험(맴브레인 필터법) (0) | 2020.08.31 |
댓글